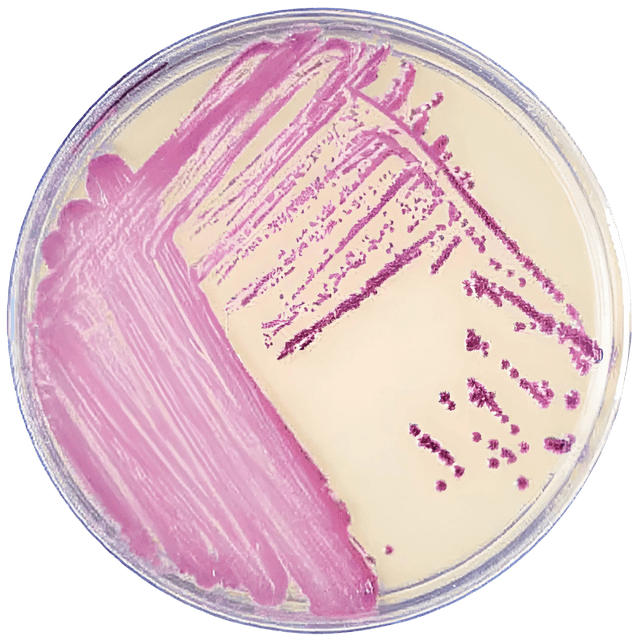
Prepared Media BD BBL™ CHROMagar™ Methicillin-resistant Staphylococcus aureus (MRSA) II Amber Mono-Plate

Prepared Media BD BBL™ CHROMagar™ Methicillin-resistant Staphylococcus aureus (MRSA) II Amber Mono-Plate
USAMP#40046704SKU: 215228BD BBL™ CHROMagar™

Product Spotlight
- BD BBL CHROMagar MRSA II is a selective and differential chromogenic medium for the qualitative direct detection of nasal colonization by methicillin-resistant Staphylococcus aureus (MRSA) to aid in the prevention and control of MRSA infections in healthcare settings
- The test is performed on anterior nares swab specimens from patients to screen for MRSA colonization
- BD BBL CHROMagar MRSA II medium permits the direct detection and identification of MRSA through the incorporation of specific chromogenic substrates and cefoxitin
- Formula: Chromopeptone 35g/L, Chromogen Mix 0.5g/L, Sodium Chloride 17.5g/L, Inhibitory Agents 7.5g/L, Cefoxitin 5.2g/L, Agar 14g/L